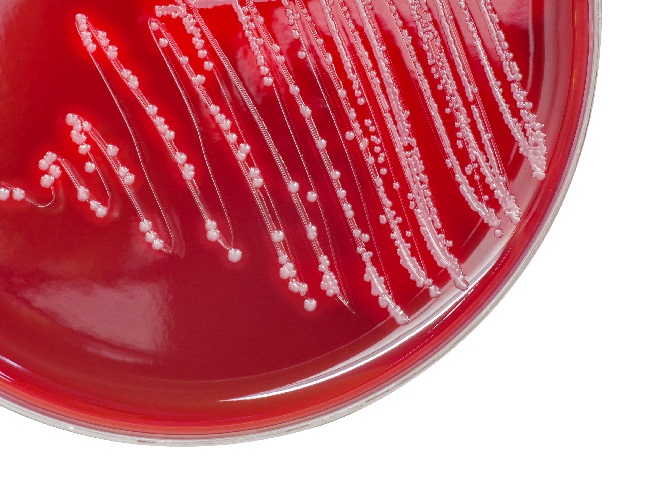
Re-thinking the causes of rheumatic fever

Highlights

High praise for MWC research from eminent scientists
Following a meeting in Auckland in February 2024, the Maurice Wilkins Centre Scientific Advisory Board, comprised of highly respected international scientists and science entrepren
read the full story

Population-specific genetic variants that alter responses to diabetes medication
A MWC programme of work around a SLC22A3 gene variant unique to Māori and Pacific peoples that could impact the way first line drug treatment is managed for people with type 2 diab
read the full story

Illuminating tumour micro environments
Advanced technical imaging capabilities and research projects supported by MWC are helping to identify new prognostic and diagnostic biomarkers to advance potential therapeutic tar
read the full story

“Immunity gap” revealed by changes in pathogen exposure during the pandemic
MWC researchers, in collaboration with the New Zealand Blood Service and CoRE Te Pūnaha Matatini, show reduced pathogen exposure altered New Zealanders’ immune status and susceptib
read the full story

MWC-China collaboration celebrates anti-cancer drug clinical trials
A longstanding relationship between MWC and Chinese researchers is celebrating its first clinical candidate undergoing Phase 1 trials. LX-132 targets many different types of cancer
read the full story

Awards recognise community reach of early career researchers
Six early career MWC-affiliated researchers are acknowledged through the MWC Early Career Steering Committee (ECSC) awards which recognise both scientific excellence and community
read the full story

Taking the stage —MWC investigators recognised
MWC Principal and Associate Investigators were awarded international and national recognition for their scientific research and engagement with the community.
read the full story

MWC community gathers in Dunedin for 2023 Symposium
MWC Investigators from across the country gathered in Dunedin for the Maurice Wilkins Centre Symposium to hear and discuss MWC strategy, research updates in the core themes of meta
read the full story

Structured engagement with Māori taking shape
MWC’s first Māori Engagement Strategy is providing a powerful foundation to propel Māori voices, projects, and researchers for impactful world-leading biomedical research.
read the full story

A step towards precision medicine for Māori and Pacific Peoples
Research funded through the MWC Metabolic Health research theme programme has led to the understanding of how a gene variant unique to Māori and Pacific could impact the way first
read the full story

PhD research unlocks less-invasive cancer testing
Only a decade ago, tracking cancer tumours with blood tests was the realm of science fiction. Now, MWC Affiliate Investigator Dr Sandra Fitzgerald has a whole technology for detect
read the full story

Clinical trials for anti-cancer agent Tarloxotinib
Maurice Wilkins Centre has supported the Tarloxotinib drug development programme over many years. Now, the Phase II clinical stage anti-cancer agent has been acquired by Convert Ph
read the full story

New anti-viral based therapies for Covid-19: Protease inhibitors
Researchers at MWC are looking to develop novel inhibitors for SARS-CoV-2 Mpro by leveraging expertise within MWC’s Infectious Disease network for anti-viral drug development.
read the full story

MWC lab part of large international effort targeting Acute Rheumatic Fever
Researchers from the University of Auckland (led by Maurice Wilkins Centre Principal Investigator Associate Professor Nikki Moreland and Affiliate Investigator Dr Reuben McGregor)
read the full story

Queenstown Research Week Teacher Scholarships
The MWC provided three secondary school science teachers the opportunity to attend the Queenstown Molecular Biology conference in partnership with the Queenstown Molecular Biology
read the full story

Awards recognise community engagement by early career researchers
Four early-career MWC-affiliated researchers are recipients of the inaugural Early Career Researcher Award Recognising Science Excellence and Community Engagement, initiated by the
read the full story

Prestigious awards recognise the work of MWC investigators
MWC Principal and Associate Investigators were awarded international and national recognition for their scientific research and engagement with the community.
read the full story

MWC celebrates future with first Māori Engagement Strategy
MWC’s first Māori Engagement Strategy will enable and guide engagement between Māori people and communities and MWC for more impactful world-leading research.
read the full story

Real time pathogen genomics for diagnostics in the Pacific
MWC is partnering with New Zealand-trained Pacific colleagues to develop diagnostics and tools for infection control and public health in the Pacific Islands.
read the full story

Unique genetic variant and mechanism drives powerful Type 2 diabetes protection
New light is shining on the role of genetics in the etiology and management of obesity and diabetes in New Zealand populations with MWC support through the Metabolic Disease Flagsh
read the full story

Following the evolving genetics of cancer
Through a broad transdisciplinary project and extensive DNA sequencing analysis, MWC scientists have identified how different metastases evolve through a variety of genetic changes
read the full story

New avenues in fight against drug resistant TB
While rising drug resistance in Mycobacterium tuberculosis is eroding the power of almost all available antibiotics in the fight against this major pathogen, work completed by MWC-
read the full story

Early career researchers spread their wings
With relaxed travel regulations, MWC resumed support for ECR visits to international laboratories. These visits help progress research in new directions, extend networks, and bring
read the full story

Teacher workshops back on the road
The MWC teacher professional development scheme supports biology teachers by helping refresh their current scientific knowledge and share high quality content with their high schoo
read the full story

TamoRx – a greater hope for a fighting chance
A spin out company focussed on developing immunotherapy medicines based on MWC research and facilities is providing hope for novel treatments to combat advanced metastatic cancer.
read the full story

MWC network plays key role in national response to COVID-19 pandemic
Investigators from across the Centre have been instrumental in developing the tools necessary to track and trace the virus, informing public health policy and measuring the ongoing
read the full story

New Otago biotech startup targets cancer
Amaroq Therapeutics, a new biotech startup company with the goal of developing targeted drugs for cancer, has been awarded significant investment funds in 2021.
read the full story

Exciting building blocks unlock peptide potential
Coined ‘bacterial super villains’, the World Health Organisation has a list of ‘priority pathogens’ which have developed resistance to most drugs. With the rise of these supe
read the full story

MWC teacher workshops focus on COVID-19
In 2020/21 the Centre adapted its teacher professional development programme to increase understanding around the COVID-19 pandemic, drawing on both MWC and national expertise to p
read the full story

Pilin protein may combat the hairy problem of human pathogens
MWC investigations into the puzzle of a nanoscopic skyscraper – ‘the pilus’ – have sparked separate lines of research into novel vaccine delivery platforms which can target differe
read the full story

Dual approach drives precision medicine
Two pioneering studies by MWC investigators are looking at the resilience and risk factors for type 2 diabetes in Māori and Pacific peoples, both ultimately aimed at understanding
read the full story

Chasing a cancer suspect to cytokinesis
A potential new way to target aggressive cancers has been identified through a MWC project as part of the research programme investigating genomic approaches to cancer diagnosis an
read the full story

Collaboration a bridge to new knowledge
Four years ago, MWC and The Moko Foundation formed the Waharoa ki te Toi Health Research Centre in Kaitaia to drive outreach including to deliver the Fructose in Schools (FIS) and
read the full story

A bountiful career of exceptional science
MWC founding Principal Investigator, Professor Bill Denny, was recognised this year with New Zealand’s highest honour.
read the full story

MWC technical excellence helps NZ attract new medicines
A high profile paper has highlighted the growing support the MWC is providing to NZ’s burgeoning clinical trials sector.
read the full story

Nationwide research flagship takes fight to global viral threats
A growing network of Maurice Wilkins Centre investigators around New Zealand are collaborating on research to tackle important viral infectious diseases.
read the full story

MWC researchers ramp up international infectious disease work
The MWC has long recognised the value in investing in research to fight infectious diseases such as tuberculosis (TB), which remains difficult to treat or prevent. MWC teams are co
read the full story

Young MWC scientists gain valuable specialist research training
Over 2019 a record number of emerging researchers took up the opportunity to access valuable specialist research training and facilities, supported by the Maurice Wilkins Centre’s
read the full story

MWC continues to lead the way in NZ cancer vaccine research
Immune therapy is one of the most exciting and promising areas of cancer research. Around New Zealand, teams of Maurice Wilkins Centre investigators – amongst them postgraduate stu
read the full story

International and national awards 2019
In yet another successful year, Maurice Wilkins Centre investigators have been recognised on the national and international stage for their contributions to science.
read the full story

New imaging improves our understanding of the immune system
Maurice Wilkins Centre researchers have used novel imaging technology to reveal the structure and inner workings of entire lymph nodes, core components of the body’s immune system.
read the full story

MWC senior leadership team welcomes new appointees
We highlight the recent appointments of three exceptional scientists – Associate Professor Rinki Murphy, Professor Debbie Hay and Dr Nikki Moreland – to the Maurice Wilkins Centre
read the full story

Developing a vaccine to prevent rheumatic fever
Group A Streptococcus (GAS) infection is widespread around the world, but causes particularly serious complications in New Zealand – especially rheumatic fever that damages th
read the full story

Celebrations as regional research centres open
The MWC continued to strengthen its relationships with Māori communities in 2018. MWC Deputy Director Professor Peter Shepherd and Principal Investigator Professor Tony Merriman, i
read the full story

Building blocks for new medicines
The MWC uses New Zealand’s outstanding medicinal chemistry expertise to discover new medicines. A particular kind of chemistry that uses natural building blocks is now being used t
read the full story

One cancer gene – but several different proteins
Cancer arises due to changes in DNA in a single cell. Many changes are needed over time to a cell’s DNA to make it cancerous – which is why cancer is usually a disease of later li
read the full story

Young MWC scientists drive upskilling of peers nationwide
The Maurice Wilkins Centre is committed to developing a new generation of scientific leaders. In 2018, our Early Career Steering Committee, a talented and vibrant group of young le
read the full story

Turning the tables on cancer
Tumours often contain areas with less oxygen than is found in normal tissues. These areas are less vulnerable to many forms of cancer therapy and often drive development of a more
read the full story

A record year for commercialisation
In 2018, NZ$58M was raised by companies in New Zealand and overseas to take MWC discoveries through to the clinic – a new record in terms of annual investment in new medicines inve
read the full story

Growing miniature human organs from stem cells
Stem cells are cells that can grow into different types of cells in the body. They sit in special zones throughout the body waiting to be called on to generate new cells. Differe
read the full story

Margaret Brimble elected a Fellow of the Royal Society of London
Professor Dame Margaret Brimble, MWC Principal Investigator at the University of Auckland, added a wonderful achievement to her exceptional scientific career in 2018 – becoming the
read the full story

Mid-term review sets future direction
A comprehensive independent assessment found the Centre to be performing at a high level, producing distinct and positive benefits for New Zealand. It also enabled re-configuration
read the full story

Flagship launches careers of young investigators
The MWC Tuberculosis Flagship research programme has proved to be a great springboard for younger investigators to progress their careers.
read the full story

Smarter drug design
An advanced experimental technique linked to high powered computation is becoming an increasingly important tool for MWC researchers developing new drugs.
read the full story

MWC salutes founding Principal Investigator
Professor John Fraser, Dean of the Faculty of Medicine and Health Sciences at the University of Auckland, has stood down from his position as Principal Investigator (PI) with the M
read the full story

High-impact publications highlight TB research
Researchers in the MWC’s Tuberculosis Flagship Research Programme have had their long hours in the lab recognised through publications in world-leading journals.
read the full story

‘Sugar in Schools’ study launched nationwide
The Maurice Wilkins Centre launched the ‘Sugar in Schools’ study in 2017 – a ground-breaking multi-year programme bringing science to thousands of schoolchildren across New Zealand
read the full story

Investigating a bacterial 'master' of disguise
MWC researchers have revealed a unique protein in a common bacterium that helps it disguise itself from immune attack. This discovery could help in development of new antimicrobial
read the full story

Working with Māori in regional research centres
MWC Deputy Director Professor Peter Shepherd and Associate Investigator Professor Tony Merriman have been instrumental in forging relationships between the Centre and Māori communi
read the full story

MWC welcomes landmark results for lung cancer drug
A novel lung cancer drug with strong development links to the MWC has shown impressive results in a large-scale international trial. Currently under review by the European Medicine
read the full story

Honouring excellence
MWC investigators received several national and international awards in 2017, celebrating and honouring their contributions to science.
read the full story

Home-grown research attracts high investor interest
Home-grown, high-tech health research from the Maurice Wilkins Centre has attracted support from local and international investors, leading to three spin-out companies in as many m
read the full story

Using 'molecular superglue' to build protein trees
Biological batteries, new vaccines and more cost-effective pharmaceuticals are just some of the potential benefits of Maurice Wilkins Centre research into the use of so-called mole
read the full story

Cells get increasing coverage
Human cells have always been important in Maurice Wilkins Centre research, but new developments open up new ground for both research and therapy.
read the full story
Re-thinking the causes of rheumatic fever
Researchers and health professionals are re-thinking the causes of rheumatic fever after studies by Maurice Wilkins Centre investigators confirmed a link between skin infections an
read the full story

Chemistry, bio and immunology combine to target immune receptor
A Maurice Wilkins Centre collaboration across several scientific disciplines has led to a patent for a new immunotherapy drug.
read the full story

Newly funded research highlights MWC collaborations
A five-year research programme aims to develop nontoxic vaccine technologies to complement existing cancer immunotherapies.
read the full story

The tumour-promoting activities of a famous protein
Developing new cancer therapies and a more reliable test for prostate cancer are just some of the potential outcomes of Maurice Wilkins Centre research into the cellular mechanisms
read the full story

New insight into an established diabetes target
Facilitating the development of better medicines for diabetes, obesity and cardiovascular disease is a key driver behind some painstaking research at the Maurice Wilkins Centre to
read the full story

Early career researchers zoom in on an important drug target
An estimated 1.3 million people die from tuberculosis (TB) each year, and new drugs are desperately needed, especially as resistance to existing drugs increases.
read the full story

Standouts on the science stage
In 2016, Maurice Wilkins Centre investigators received a number of national and international honours in recognition of their services to science.
read the full story

Making the most of New Zealand’s resources
The Maurice Wilkins Centre is facilitating access to specialised equipment and facilities across the nation with a new scheme that makes the most of New Zealand’s research resource
read the full story

Mapping microscopic worlds
Maurice Wilkins Centre researchers have used unique microscopic imaging techniques to peer into the three-dimensional structure of blood vessel networks – and new computational tec
read the full story

Pursuing a dynamic research career
A chance project as an undergraduate led early career researcher Dr Wanting Jiao to the world of computational modelling where she developed the skills needed by a number of Mauric
read the full story

MWC leads cancer immune therapy conversation
The Maurice Wilkins Centre continues to be part of an international drive to develop and improve immune therapy for cancer. In 2015 the Centre organised a symposium that brought to
read the full story

New Zealand TB research tackles international problem
A 2014 pilot study funded by the Maurice Wilkins Centre’s Flexible Research Programme has led to a larger investigation into the genetics of drug-resistant tuberculosis (TB) in Ind
read the full story

China collaborations go from strength to strength
The Maurice Wilkins Centre continues to lead the way in establishing biomedical research ties between New Zealand and China. 2015 marked important developments in relations that wi
read the full story

Genetic study challenges popular opinion
A new Maurice Wilkins Centre study is bringing together researchers from across the country to investigate the genetic factors that predispose some New Zealanders to a greater risk
read the full story

NZ chemists provide expertise to tackle neglected disease
For Maurice Wilkins Centre associated chemists at the Auckland Cancer Society Research Centre, what started as the development of an anti-TB drug has morphed into the discovery of
read the full story

International recognition for MWC investigators
In 2015 Maurice Wilkins Centre investigators received a number of international awards that recognised their achievements in research and community service.
read the full story

Cancer drug advances to phase II clinical trials
A New Zealand cancer drug developed by two Maurice Wilkins Centre investigators has reached the second phase of clinical trials with patients.
read the full story

Cross fertilising the new CoREs (2014)
In November 2014, the Maurice Wilkins Centre came together with the MacDiarmid Institute to organise a combined Centres of Research Excellence symposium at the University of Auckla
read the full story
Teacher programme reignites passion for science (2014)
Biology teacher Erin Sycamore is a big fan of MWC teacher professional development days and the annual biological conference in Queenstown. She shares her experiences and delight o
read the full story

International scheme brings top technology home (2014)
Since 2011, MWC’s international training programme has given young New Zealand researchers access to facilities across the world. Young scientists benefit from exposure to the late
read the full story

Advanced technology leads to discovery of a new cell in human skin (2014)
MWC scientists have developed new methods to identify the different types of cells in human tissues – including very rare ones.
read the full story

The intriguing matter of cracking bacterial bonds (2014)
Maurice Wilkins Centre investigators at the University of Auckland are world leaders in discovery of new cross-links in proteins.
read the full story

Expanding NZ's international reach (2014)
Relationships with prestigious research institutes overseas continue to strengthen.
read the full story

New drug discovery a New Zealand first (2014)
Distinguished Professor Margaret Brimble is proud of her discovery, for women, by a woman.
read the full story

Eminent founding Director looks back (2014)
As the founding director of the MWC moves into retirement, he talks of the triumph of relationships and the importance of simply “getting started”.
read the full story

Maurice Wilkins Centre funding renewed (2014)
Maurice Wilkins Centre is one of two Centres for Research Excellence to have their funding renewed.
read the full story

New therapies - from a new generation (2013)
Nurturing the next generation of scientists is an important part of the Maurice Wilkins Centre’s work – and senior students contribute an enormous amount to research success.
read the full story
Teacher development, from Kaitaia to Invercargill (2013)
This year the Maurice Wilkins Centre expanded its programme of professional development days for science teachers.
read the full story

Partnerships boost business: MWC supports Auckland Clinical Studies (2013)
The Maurice Wilkins Centre provides world-class support for medical trials provider Auckland Clinical Studies, helping to cement New Zealand’s growing reputation as a good place to
read the full story

New chemistry transforms cancer vaccine (2013)
A new kind of chemistry that dramatically simplifies the manufacture of cancer vaccines was created this year by Honours student Tom Wright.
read the full story

A fresh approach to diabetes (2013)
Type 2 diabetes is often caused by obesity, and weight-loss surgery usually reverses it. However, we don’t know precisely how this happens, and a new study at the MWC aims to find
read the full story

Advancing a vaccine for rheumatic fever (2013)
In 2013 the Maurice Wilkins Centre hosted a symposium attended by world experts in rheumatic fever. It marked the start of a trans-Tasman collaboration to eliminate the disease by
read the full story

New strategic alliance with China (2013)
Maurice Wilkins Centre investigators lead two research grants awarded in 2013 under the New Zealand-China Strategic Research Alliance (SRA).
read the full story

Stepping up the fight: The Tuberculosis Flagship (2013)
The Maurice Wilkins Centre is behind the launch of a national research network of ‘serious intellectual muscle’ that aims to speed up action against tuberculosis.
read the full story

Spreading the word (2013)
This year Maurice Wilkins Centre investigator Dr Siouxsie Wiles not only won the Callaghan Medal for science communication, awarded by the Royal Society of New Zealand, but also th
read the full story

New MWC PhD scholarships
Prestigious MWC PhD Scholarships available for 2015
read the full story

International award for New Zealand drug inventor (2013)
Maurice Wilkins Centre principal investigator Distinguished Professor Bill Denny has been named the recipient of the American Chemical Society’s 2014 Medicinal Chemistry Award.
read the full story

Stem cell pioneer delivers "knockout" lecture (2009)
Stem cells have the capacity to replenish any type of cell in the body. It’s this quality that gives stem cells the potential to transform modern medicine and excites so much inter
read the full story

Major new cancer vaccine programme (2010)
Maurice Wilkins Centre investigators are involved in a major new research programme that aims to develop and trial anti-cancer vaccines in New Zealand.
read the full story

New technologies for imaging the human body (2012)
New Zealand technologies being developed to perform delicate new procedures, locate sites where cancer drugs are active, and model a person’s entire skin, were just some of the top
read the full story

PhD student part of international drug development programme (2012)
Maurice Wilkins Centre-funded PhD student Matthew Bull is part of international research on a new class of immunosuppressants being developed initially to protect bone marrow trans
read the full story

The future of vaccines (2012)
Maurice Wilkins Centre investigator Professor Sarah Hook from the University of Otago is developing new vaccine formulations – including needle-free vaccines and vaccines for cance
read the full story

New Zealand TB drug candidate selected (2012)
In late 2012 a promising New Zealand compound targeting treatment-resistant tuberculosis (TB) was selected as a drug candidate by international non-profit drug developer the Global
read the full story

A licence to manufacture medicines (2012)
A licence to manufacture medicines has been granted to a University of Auckland facility that will produce the active ingredients of cancer vaccines to be tested in humans. The fac
read the full story

Rheumatic fever - Research strengths confront national need (2012)
The Maurice Wilkins Centre prioritises rheumatic fever research, and its work built momentum in 2012 with the appointment of a specialist researcher, funding of two research projec
read the full story

Creating connections with China (2012)
An official visit by State Councillor Liu Yandong, now a Vice-Premier of the People’s Republic of China, was the culmination of the Maurice Wilkins Centre’s work during 2012 to bui
read the full story

A core of celebrated scientists (2012)
Maurice Wilkins Centre investigators continued to win acclaim in 2012, ending the year with seven medals at the Royal Society of New Zealand research honours event, including the t
read the full story

International opportunity for young scientists (2011)
In 2011 the Maurice Wilkins Centre launched a new scheme to help its early-career scientists train in cutting-edge technology – and share what they have learned with New Zealand co
read the full story

School students get into hot water (2011)
With a blessing from Ngati Hei – and a polite request for tourists to move from their bathing holes – a unique experiment got underway at Hot Water Beach on the Coromandel Peninsul
read the full story

Mirror-image proteins - new biology from new chemistry (2011)
Maurice Wilkins Centre investigators are working with a pioneering international chemist to develop new methods for virus and drug research.
read the full story

A new toolkit for building virtual humans (2011)
The Auckland Bioengineering Institute (ABI), established by Maurice Wilkins Centre cofounder Professor Peter Hunter, is a lead player in international efforts to build comprehensiv
read the full story

New inhibitor for tuberculosis (2011)
A new way to shut down the bacterium responsible for tuberculosis has been devised by researchers in one of the Maurice Wilkins Centre’s longest-standing collaborations.
read the full story

Dissecting drug side effects offers hope (2011)
Researchers from the Maurice Wilkins Centre have discovered how a common class of medicines causes diabetes-like symptoms, and their work suggests a promising way of managing these
read the full story

Exquisite networks (2011)
Innovative technology developed to study the heart has been adapted for a unique study of the immune system – and will now be applied to cancer, through cross-disciplinary links fo
read the full story

Virtual screening boosts drug discovery (2010)
A high-powered new virtual environment that allows researchers to screen thousands of molecules as potential new drug leads was launched in 2010, providing a major boost to Maurice
read the full story

Supporting New Zealand’s future scientists (2010)
The inaugural Future Science Day convened by the Maurice Wilkins Centre in 2010 provided advice, mentorship, networking, and science communication opportunities to 150 New Zealand
read the full story

Modern approaches to an ancient disease (2010)
Scientists associated with the Maurice Wilkins Centre have created new drugs for tuberculosis.
read the full story

Mapping cellular networks (2010)
Maurice Wilkins Centre PhD student Daniel Hurley and colleagues are mapping signalling networks in cancer and have identified “master regulators” associated with patient survival.
read the full story

Joining forces against infectious disease (2010)
The 2010 Superbugs Symposium convened by the Maurice Wilkins Centre brought together more than 350 medical professionals and scientists fighting infectious disease.
read the full story

Drug selection a milestone for spin-out (2010)
In 2010 Maurice Wilkins Centre investigators Professors Bill Denny and Peter Shepherd selected a new anticancer drug candidate for clinical development, triggering US $4.5 million
read the full story

Doctoral students win international recognition (2010)
Two medicinal chemistry PhD students supervised by Maurice Wilkins Centre investigator Professor Margaret Brimble have won prestigious international postdoctoral fellowships.
read the full story

Clues to life-threatening organ failure (2010)
Relatively little is known about lymph but there is growing evidence that it can carry disease-causing toxins from the intestines throughout the body. Researchers associated with t
read the full story

Study exposes superbug defences (2009)
An international study between scientists from New Zealand and Denmark has revealed exactly how the bacterium Staphylococcus aureus evades the human body’s key immune defences.
read the full story

Professor Peter Hunter awarded nation’s top science honour (2009)
Professor Peter Hunter was presented with the prestigious 2009 Rutherford Medal at the Royal Society of New Zealand’s annual Science Honours Dinner.
read the full story

Mixing with Asia’s best and brightest (2009)
The Maurice Wilkins Centre sponsored two secondary school students and a teacher to attend an Asian regional science camp.
read the full story

Lighting up lymph nodes (2009)
Maurice Wilkins Centre researchers have made exciting new discoveries about how human lymph nodes work.
read the full story

Kidney cancer researcher scores a first for New Zealand (2009)
In December 2009, Maurice Wilkins Centre investigator Associate Professor Michael Hay became the first New Zealand scientist to receive a grant from a leading international charity
read the full story

Help with difficult diagnoses (2009)
Maurice Wilkins Centre technology is helping Auckland Hospital with difficult diagnoses.
read the full story

First doctoral students – where are they now? (2009)
In 2008, the first students to receive full scholarships from the Maurice Wilkins Centre graduated with their PhDs.
read the full story

Crystals of mirrored proteins (2009)
Maurice Wilkins Centre researchers are using an exciting new crystallisation technique to reveal the structure of proteins.
read the full story

Creating connections between drug discovery and business (2009)
The Maurice Wilkins Centre hosted the New Zealand Drug Discovery Symposium in September 2009, bringing together more than 450 delegates from science, medicine, business, and ventur
read the full story

A blossoming collaboration with Japan (2011)
Formal relationships between the Maurice Wilkins Centre and high-profile Japanese research institutions were established in 2011, and exchange visits have already begun.
read the full story

Scientists and teachers in unique partnership (2012)
Science teachers from Auckland and Northland leapt at the opportunity for an intensive update on the latest in biomedical science, at a unique Maurice Wilkins Centre event in 2012.
read the full story

Cancer stealth drug enters clinical development (2010)
The first of an exciting new class of anticancer drugs will proceed to clinical development under an international deal announced in early 2011.
read the full story

New Zealand patients trial local cancer drug (2012)
Cancer patients in Auckland, Waikato and the United States are participating in the first clinical trial of an exciting new drug invented in New Zealand.
read the full story

New drug targets treatment-resistant cancer (2011)
A new drug targeting an important group of cancer cells attracted international funding in 2011 and will soon enter clinical trials.
read the full story

The future of healthcare is already here (2011)
Tailoring a person’s medical care to their genetic makeup may sound like science fiction, but “personalised medicine” is already here – as scientists and health professionals discu
read the full story

MWC enters exciting new era of collaboration with Pacific health partners
The Maurice Wilkins Centre (MWC) signed landmark agreements with two Pacific health research partners in 2019 – the Scientific Research Organisation of Samoa and Pacific Health Plu
read the full story